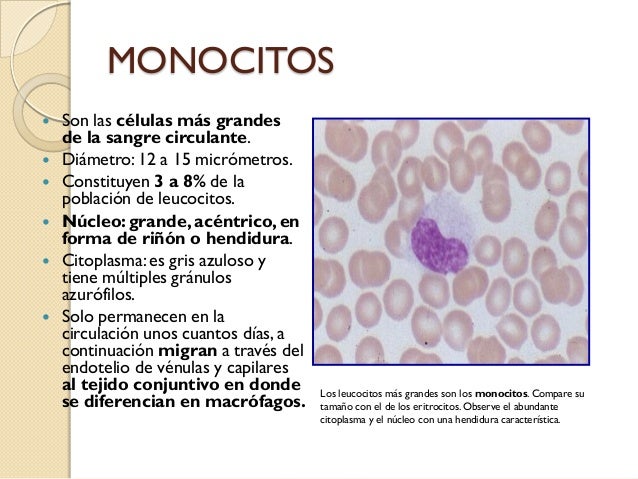
Que Son Los Monocitos En La Sangre es.slideshare.net

Que Son Los Monocitos En La Sangre

¿Qué son los monocitos en la sangre? Son un tipo de glóbulo blanco, esenciales para el sistema inmunitario. Actúan como "limpiadores" y "mensajeros". Se producen en la médula ósea y circulan en la sangre hasta que migran a los tejidos, donde se transforman en macrófagos o células dendríticas. Estas células "comen" bacterias, virus, células muertas y otros desechos, protegiéndonos de infecciones y enfermedades. También, presentan antígenos a otros glóbulos blancos, activando una respuesta inmunitaria más específica.
Entendiendo el Papel de los Monocitos:
Los monocitos son cruciales para:
- Defensa contra infecciones: Ingieren y destruyen patógenos como bacterias, hongos y virus. Imagina que son como Pac-Man, comiéndose a los "fantasmas" (gérmenes) dentro del cuerpo.
- Eliminación de tejido dañado: Limpian las células muertas y los desechos celulares, ayudando a la reparación de tejidos después de una lesión o inflamación. Piensa en ellos como el equipo de limpieza después de una fiesta, dejando todo impecable.
- Regulación del sistema inmunitario: Presentan antígenos a otros glóbulos blancos, como los linfocitos T, iniciando una respuesta inmunitaria más precisa y eficiente. Actúan como presentadores, mostrando a otros defensores qué enemigo atacar.
¿Qué Significan los Niveles de Monocitos?
Un análisis de sangre mide la cantidad de monocitos. Los niveles pueden indicar problemas:
- Monocitos altos (Monocitosis): Podría indicar una infección crónica, una enfermedad autoinmune (como lupus o artritis reumatoide), inflamación, o incluso algunos tipos de cáncer. Es como si el equipo de limpieza estuviera trabajando horas extras debido a un problema persistente.
- Monocitos bajos (Monocitopenia): Podría ser causado por una infección grave, problemas en la médula ósea o ciertos medicamentos. Es como si faltaran miembros importantes del equipo de limpieza, debilitando la defensa del cuerpo.
Es importante recordar que los resultados del análisis de sangre deben ser interpretados por un médico. Si tienes dudas sobre tus niveles de monocitos, consulta a un profesional de la salud para un diagnóstico y tratamiento adecuados. El análisis en sí no es un diagnóstico, es solo una pieza del rompecabezas.